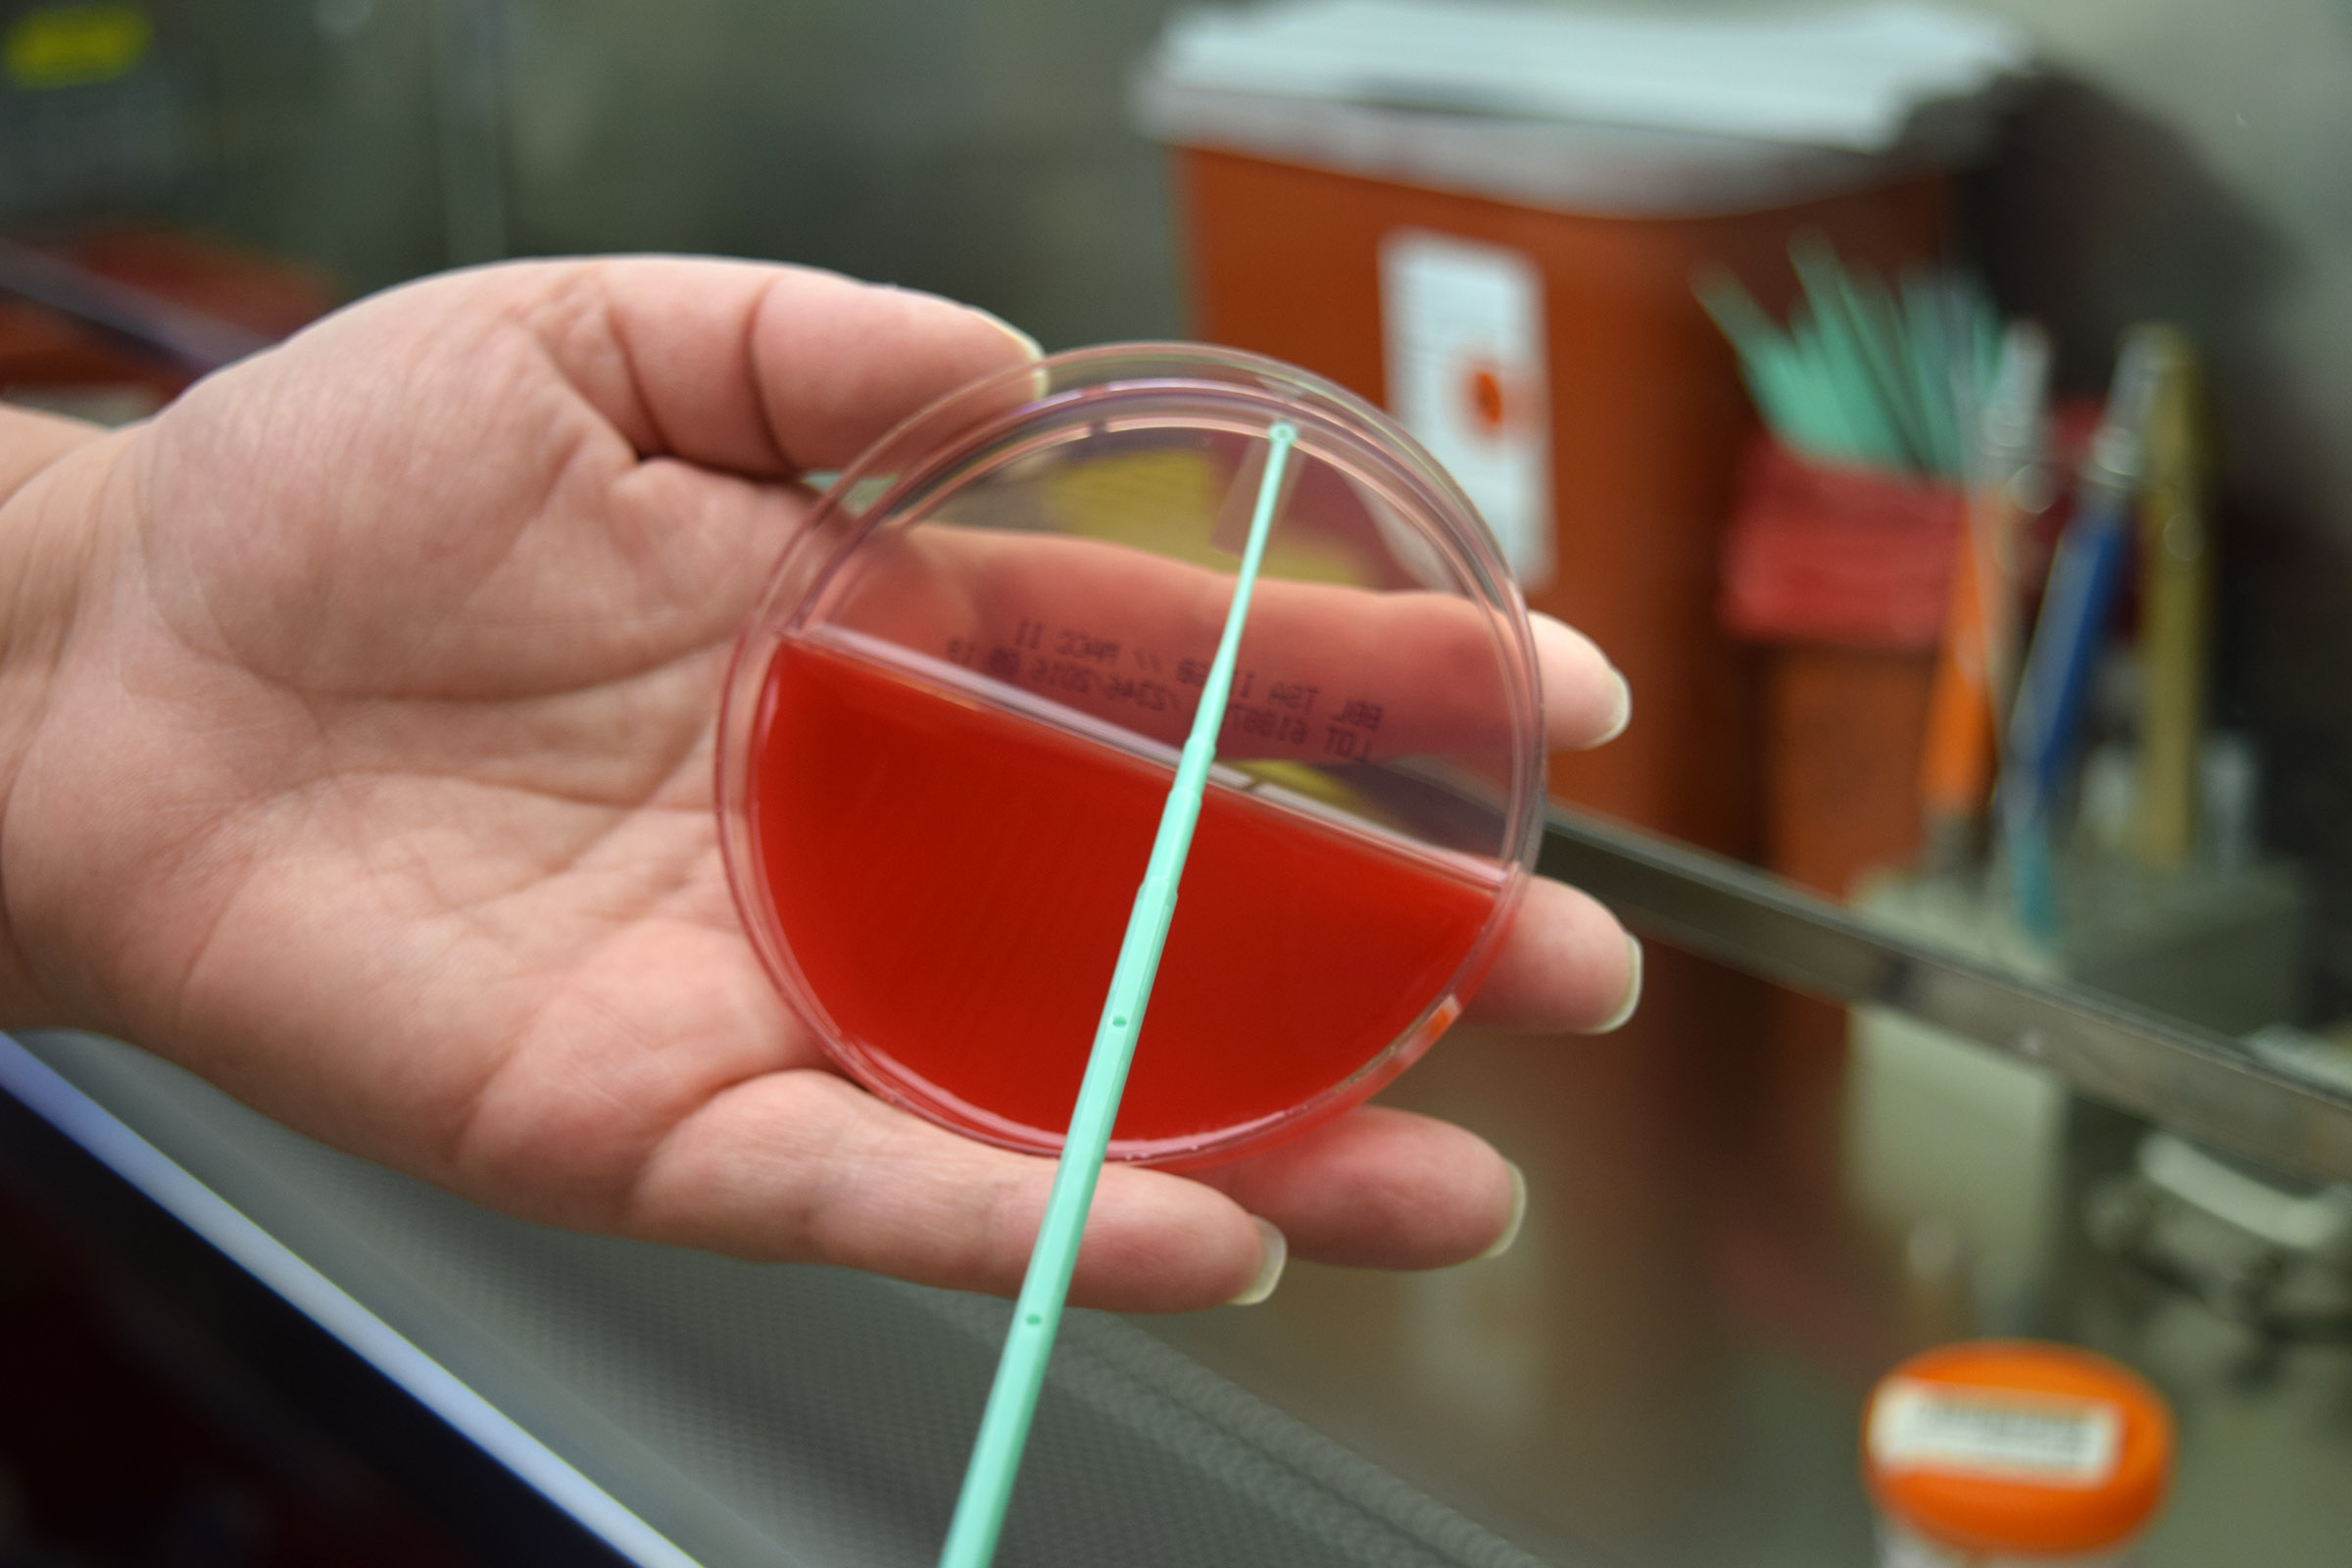

'Memories of Marilyn' Event to Honor the Late Dr. Menegus
Just about everyone who knew or worked with Dr. Marilyn Menegus (1943-2017) has a story about her.
There was the time she brought a Cheesy Eddie’s carrot cake to work when she got tired of hearing that her staff had never tried it before. A colleague recalled the way she could cut through complex scientific concepts and make them easy for anyone to understand. And her coworkers can remember how she’d warmly greet them with, “Hey kid,” no matter their age.
Dr. Menegus, known to many as, simply, Marilyn, passed away March 20, 2017 from complications resulting from colon cancer. Since then, the response from those who knew her has been felt deeply by many.
To celebrate her life and legacy, the Department of Pathology & Laboratory Medicine will host an informal event at the University of Rochester Medical Center on Friday, May 12.
Marilyn was an extremely accomplished and well respected microbiologist who joined the Department of Microbiology and Immunology in 1976 with a secondary appointment in Pathology & Lab Medicine.
She trained more than 40 clinical microbiology fellows and five infectious disease fellows during her 41 years at URMC, earning her the title of “mother of the post-doc program.” She stayed in contact with many of her past trainees, whom she treated like family. Many went on to work in prestigious laboratories across the U.S. Her impact on their professional lives remains strong.
“She was truly a mentor, always eager to share interesting clinical cases and inserting educational tidbits along the way,” said former fellow, Kristen Smith, Ph.D. “The depth of her knowledge and passion always amazed me.”
Former Pathology resident Vanesa Bijol, M.D., who now works in the Harvard University health system, said the sheer number of lives touched by Marilyn was huge. “In that sense, her professional impact was huge, and very few of us who devote life to academia can achieve that level of success,” Bijol wrote. “But she never thought of it that way. She just simply enjoyed her work, science, and teaching, and was very humble about her achievements.”
Marilyn was born and raised in Passaic, New Jersey with siblings, Dorothy and Herbert. She earned her bachelor’s degree from the College of Saint Elizabeth and later received her Ph.D. in virology from Cornell University in 1971.
In her early career, she established a clinical virology laboratory at St. Luke’s Hospital in New York City and also founded a clinical virology lab at URMC, which was one of the few of its kind in the U.S. during the late 1970s. During the course of her career, she published more than 100 articles and book chapters as an author and co-author.
She was an active member of organizations including the American Academy of Microbiology, and the American Society for Microbiology. In 2013 she received the Diagnostic Virology Award from the Pan American Society for Clinical Virology.
In what became one of her final professional contributions, Marilyn worked closely with the Finger Lakes Donor Recovery Network to establish a nucleic acid testing lab at Strong Memorial Hospital to significantly expedite the organ transplant process for organ recipients. This was launched successfully in February just weeks before her passing.
Rob Kochik, executive director of FLDRN, said he was heartbroken to hear the news of Marilyn’s death.
“She was always such a joy to work with,” he wrote. “She was committed to helping establish the NAT testing facility because she truly understood how vitally important it was to help the donation process.”
Despite her expertise and accomplishments, many remember Marilyn as an extremely approachable and down to earth person; a lover of gardening, food, wine, and a good joke.
Her brother describes her as “fiercely independent” and a rule breaker at heart. This was evidenced by one of her favorite movies, “Ferris Buehler’s Day Off,” and a stack of unpaid red light tickets.
An avid gardener, she once served as president of the Genesee Region Orchid Society and had more than 200 orchids in her house, in addition to a lush garden at her Rochester home where she lived with two cats, Bella and Luigi, and frequently hosted parties for friends.
Whether you knew her for 20 years or 20 minutes, Marilyn made a warm and lasting impression on the people she encountered at or outside of work. Debra Jesien, chief supervisor of Clinical Microbiology at URMC, worked closely with Marilyn for many years.
“She could bond with people very quickly,” said Jesien. “She was the type of person you could talk to once and you felt like you knew her.”
EVENT INFO:
What: Memories of Marilyn, an informal memorial to celebrate the life of Dr. Marilyn Menegus. Guests are encouraged to bring their stories and photos to share.
When: Friday, May 12 from 12:00-2:00 p.m.
Where: LeChase Assembly Hall (G-9576) University of Rochester Medical Center. Drinks and light refreshments will be provided.
RSVP: Please follow this link to enter your RSVP online or contact Bethany Bushen for more information.
Read the obituary of Dr. Menegus in the Democrat and Chronicle
Bethany Bushen | 4/26/2017